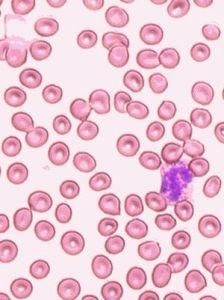
紅細胞計數

簡介
紅細胞計數英文名稱:RedBloodCellCount.
英文又名:RBC
中文名稱:紅細胞計數
英文名稱:RBC
化驗介紹
正常情況下,紅細胞的生成和破壞處於動態平衡咽而血液中,因而血液中紅細胞的數量及質量保持相對穩定。無論何種原因造成的紅細胞生成與破壞的失常,都會引起紅細胞在數量上或質量上的改變,從而導致疾病的發生。
臨床意義
情況分析
紅細胞增多見於:
真性紅細胞增多症⑴嚴重嘔吐、腹瀉、大面積燒傷及晚期消化道腫瘤患者。多為脫水血濃縮使血液中的有形成分相對地增多所致。
⑵心肺疾病:先天性心臟病、慢性肺臟疾患及慢性一氧化碳中毒等。因缺氧必須藉助大量紅細胞來維持供氧需要。
⑶幹細胞疾患:真性紅細胞增多症。
紅細胞減少見於:
⑴急性或慢性失血。
⑵紅細胞遭受物理、化學或生物因素破壞。
⑶缺乏造血因素、造血障礙和造血組織損傷。
⑷各種原因的血管內或血管外溶血。
正常值:
正常參考值:顯微鏡統計數法:M(男):400萬-550萬/μlF(女):350萬-500萬/μl血球計數儀:兒童600萬-700萬/μl
顯微鏡計數法:手指血10微升
自動血細胞分析儀:靜脈血1~2ml,EDTA-K2抗凝
生理情況下,人體每天約有1/120紅細胞衰亡,同時,又有1/120的紅細胞產生,使紅細胞的生成與衰亡保持動態平衡。多種原因可使這種平衡遭到破壞,導致紅細胞和血紅蛋白數量減少或增多。
紅細胞計數臨床意義
⑴生理性變化a年齡與性別差異:
新生兒:2周后逐漸下降
兒童:男性兒童6~7歲時最低,然後隨年齡增大上升,25~30歲達高峰,此後逐漸下降
女性兒童13~15歲達高峰,然後受月經、內分泌等影響逐漸下降,21~35歲最低,然後逐漸增高與男性相近。因此在15~40歲之間兩性紅細胞計數差別最大。可能與睪酮促進紅細胞造血有關。
b精神因素:興奮、激動、恐懼、冷水浴等伴隨腎上腺素增多,可導致紅細胞暫時性增多。
c劇烈體力運動和勞動:相對缺氧引起促紅細胞生成素生成增加,骨髓加速釋放紅細胞。
d氣壓降低:缺氧刺激紅細胞代償增生,高海拔地區
e妊娠中、後期血液稀釋使紅細胞減少;6個月~2歲嬰幼兒生長發育迅速導致造血原料相對缺乏;某些老年人造血功能明顯減退等
病理性變化
a紅細胞和血紅蛋白減少:最常見於各種原因的貧血。按照病因,可將貧血分成三大類①急性、慢性紅細胞丟失過多:如各種原因的出血,見於消化性潰瘍、痔瘡、十二指腸鉤蟲病等
②紅細胞壽命縮短:如各種原因的溶血
紅細胞膜缺陷:球形細胞增多症;遺傳性橢圓形細胞增多症;口形紅細胞增多症;棘形紅
細胞增多症;陣發睡眠性血紅蛋白尿
紅細胞酶缺陷
如無氧酵解途徑紅細胞酶缺陷如丙酮酸激酶缺陷,缺乏磷酸戊糖旁路或谷胱甘肽代謝所需酶,葡萄糖-6-磷酸脫氫酶變異等。血清中抗體或補體影響:自體免疫溶血貧,藥物誘發溶血貧、血型不合輸血致溶血等
機械損傷:微血管病性溶血貧,行軍性血紅蛋白尿,創傷性心源性溶血貧
化學、物理、生物因素:化學毒物及藥物引起溶血、大面積燒傷、感染、溶血性蛇毒
脾臟內阻留:脾亢
③紅細胞生成減少:
造血幹細胞和造血微環境損害:再障
紅系祖細胞、幼紅細胞或紅細胞生成素的免疫破壞:純紅再障
骨髓被異常組織或細胞浸潤
DNA合成障礙如葉酸、B12缺乏導致的巨幼貧
紅細胞生成素產生障礙如慢性疾病(炎症、腎功不全)
血紅素合成障礙如缺鐵性貧血、鐵粒幼細胞性貧血、鉛中毒性貧血。
珠蛋白合成障礙如鐮形細胞性貧血、血紅蛋白C、D、E病、珠蛋白生成障礙性貧血
b紅細胞增多:
原發紅細胞增多:真性紅細胞增多症,良性家族性紅細胞增多症等
繼發性紅細胞增多:見於各種引起低氧血症的疾病如各種先心病(室缺、法四)、肺疾病(肺氣腫、肺心病、肺纖維化)、異常血紅蛋白病、腎上腺皮質功能亢進等。藥物如腎上腺素、糖皮質激素、雄激素可引起紅細胞數的增加相對性紅細胞增多:由於血液水分的丟失如嘔吐、嚴重腹瀉、多汗、多尿、大面積燒傷、等引起血液濃縮。
正常值
血細胞自動計數儀、顯微鏡計數法:
成 人:男性(4.0~5.5)×1012/L(400萬~550萬/mm3)
女性(3.5~5.0)×1012/L(350萬~500萬/mm3)
新生兒:(6.0~7.0)×1012/L (600萬~700萬/mm3)
嬰 兒抅:(5.2~7.0)×1012/L
兒 童:(4.2~5.5)×1012/L
異常結果分析
紅細胞和血紅蛋白增多:
導致紅細胞和血紅蛋白數量減少或增多1.相對性增多:由於某些原因使血漿中水分丟失,血液濃縮,使紅細胞和血紅蛋白含量相對增多。如連續劇烈嘔吐、大面積燒傷、嚴重腹瀉、大量出汗等;另見於慢性腎上腺皮質功能減退、尿崩症、甲狀腺功能亢進等。
2.絕對性增多:由各種原因引起血液中紅細胞和血紅蛋白絕對值增多,多與機體循環及組織缺氧、血中促紅細胞生成素水平升高、骨髓加速釋放紅細胞有關。
⑴生理性增多:見於高原居民、胎兒和新生兒、劇烈勞動、恐懼、冷水浴等。
⑵病理性增多:由於促紅細胞生成素代償性增多所致,見於嚴重的先天性及後天性心肺疾病和血管畸形,如法洛四聯症、紫紺型先天性心臟病、阻塞性肺氣腫、肺源性心臟病、肺動-靜脈瘺以及攜氧能力低的異常血紅蛋白病等。
在另一些情況下,病人並無組織缺氧,促紅細胞生成素的增多並非機體需要,紅細胞和血紅蛋白增多亦無代償意義,見於某些腫瘤或腎臟疾病,如腎癌、肝細胞癌、腎胚胎瘤以及腎盂積水、多囊腎等。
紅細胞和血紅蛋白減少:
一般成年男性血紅蛋白<120g/L,成年女性血紅蛋白<110g/L為貧血。根據血紅蛋白減低的程度貧血可分為四級。輕度:血紅蛋白<90g/L、中度:血紅蛋白90~60g/L、重度:血紅蛋白60~30g/L、極度:血紅蛋白<30g/L。
1.生理性減少:3個月的嬰兒至15歲以前的兒童,因生長發育迅速而致造血原料相對不足,紅細胞和血紅蛋白可較正常人低10%~20%。妊娠中、後期由於孕婦血容量增加使血液稀釋,老年人由於骨髓造血功能逐漸減低,均可導致紅細胞和血紅蛋白含量減少。
2.病理性減少:
⑴紅細胞生成減少所致的貧血:
1)骨髓造血功能衰竭:再生障礙性貧血、骨髓纖維化等伴發的貧血。
2)因造血物質缺乏或利用障礙引起的貧血:如缺鐵性貧血、鐵粒幼細胞性貧血、葉酸及維生素B12缺乏所致的巨幼細胞性貧血。
⑵因紅細胞膜、酶遺傳性的缺陷或外來因素造成紅細胞破壞過多導致的貧血,如遺傳性球形紅細胞增多症、地中海性貧血、陣發性睡眠性血紅蛋白尿、異常血紅蛋白病、免疫性溶血性貧血、心臟體外循環的大手術及一些化學、生物因素等引起的溶血性貧血。
⑶失血:急性失血或消化道潰瘍、鉤蟲病等慢性失血所致的貧血。
分類
血液經抗凝處理後,通過離心可以把血液分為兩大部分,血漿和血細胞。如果將血液放在一個特殊的試管中(溫氏管)按規定的時間和速度進行離心,最終使得紅細胞完全壓實在試管的底端,紅細胞之間互相接觸密切,儘可能排除所有血漿,此時血漿會全部被擠出到血細胞的上面,這時紅細胞所占全血的百分比就是我們所要得到的紅細胞壓積,即壓實的紅細胞所占的體積數(或百分比),也叫紅細胞比積或紅細胞比容。測定紅細胞壓積還可用毛細管法和血細胞計數儀法測定。紅細胞壓積通常縮寫為HCT或Ht,測定單位現在多用每升血液中紅細胞占有多少升來表達(L/L)。紅細胞壓積的測定有助於了解紅細胞的增多與減少,當各種原因所致的紅細胞絕對值增高時,紅細胞壓積也會有相應的增加。血液濃縮時紅細胞壓積可達50%以上,臨床上常用於了解脫水病人的血液濃縮程度,作為計算補液量的參考。紅細胞壓積降低於各種貧血有關,因紅細胞體積大小的不同,紅細胞壓積的改變並不與紅細胞數量平行,需同時測定紅細胞數量和血紅蛋白濃度,並用於計算紅細胞各項平均值才有參考價值紅細胞計數(RBC)。
處方
缺鐵性貧血2.貧血病人不可偏食,注意經常進食含鐵及葉酸豐富的食物,如綠色蔬菜、蛋、肉、魚、水果等。
3.小兒生長發育期和婦女妊娠期、哺乳期造血物質需要量大,應加強營養,如食物補充不夠,可在醫生指導下口服鐵劑和葉酸。
4.月經量過多的婦女也要及時補充鐵劑,應查明有否婦科疾病,先治好婦科病,堵住出血漏洞,貧血才能恢復。有痔瘡出血或鉤蟲病的病人,應及時治療,否則長期慢性出血也會導致缺鐵性貧血。
5.胃、小腸手術後病人,慢性胃炎胃酸減少者會引起造血因子缺乏,應注意檢查,如發現有貧血應積極治療。
6.老年人發生貧血一定要去醫院查清病因,以防遺漏腫瘤性疾病。
貧血是指循環血液中紅細胞數和血紅蛋白量低於正常。中國正常人紅細胞數男性為400~550萬/立方毫米,女性為350~500萬/立方毫米;血紅蛋白男性為12~16克%,女性為11-15克%。一般認為男子紅細胞數低於400萬/立方毫米,血紅蛋白量低於12克%女性紅細胞數低於350萬/立方毫米,血紅蛋白量低於10.5克%為貧血。
紅細胞內除水分外主要含血紅蛋白,所以血液里紅色。血紅蛋白的主要功能是輸送氧和二氧化碳。貧血時紅細胞數明顯減少,運載氧氣的能力減弱,結果使組織細胞缺氧,引起貧血的各種症狀:蒼白、頭暈、耳鳴、記憶力減退、四肢軟弱無力、食欲不振、腹脹、活動後氣息、心跳加快、心臟搏動增強等;嚴重者可引起貧血性心臟病、心力衰竭。貧血症狀的輕重主要取決於貧血的程度和產生貧血的原因和速度,產生貧血的速度越快症狀越嚴重,而緩慢出現的貧血由於人體的適應和代償,症狀相對要輕得多。貧血可由多種原因引起。要了解貧血的原因,必須先了解紅細胞在體內不斷更新的過程。紅細胞在循環血液中的壽命大約為120天,衰老的紅細胞主要在脾臟內被清除。骨髓是成人製造紅細胞的工廠。幼稚紅細胞在骨髓內發育成長,成熟後不斷被輸送到血循環里,保持循環血液中紅細胞和血紅蛋白量的恆定。因而紅細胞生成減少或紅細胞損失過多則是產生貧血的兩大原因。
1.紅細胞生成減少骨髓造血功能減退,可引起再生障礙性貧血或單純紅細胞性再生障礙性貧血;骨髓被異常組織侵害,引起骨髓病性貧血;造血原料缺乏,如缺鐵性貧血,營養性大細胞性貧血。
⒉紅細胞損失過多各種原因引起的紅細胞壽命縮短,過多、過速地破壞,即產生溶血性貧血;失血過多引起失血性貧血。此外,慢性感染、腫瘤、腎炎、尿毒症、肝病、內分泌功能減退等均可伴有貧血症狀,這類貧血稱繼發性貧血。正因為貧血可由多種原因引起,因此必須查明每個病人發生貧血的確切原因,才能得到合理的治療。萬能的補血藥物是不存在的。
相關疾病
1. 一氧化碳中毒 (煤氣中毒)
2. 不穩定血紅蛋白病 (不穩定性血紅蛋白病)
3. 丙酮酸激酶缺乏症
4. 產後出血
5. 傳染性淋巴細胞增多症
6. 便血 (腸風便血;圊血;下消化道出血;hemorrhage of lower digestive tract;having blood in one's stool;hemafecia)
7. 兒童色素沉著息肉綜合徵 (兒童口周雀斑樣痣病;兒童色素沉著-胃腸息肉綜合徵;兒童黑色素斑-胃腸多發性息肉綜合徵;兒童Peutz-Jeghers綜合徵;juvenile periorificial lendiginosis;juvenile pigmentation-gasfrointestinal polyposis syndrome; juvenile Peutz-Jeghers syndrome)
8. 先天性紅細胞生成異常性貧血 (先天性紅細胞生成不良性貧血;遺傳性良性網織紅細胞增生性貧血)
9. 先天性腎盂輸尿管連線部梗阻
10. 內臟利什曼病 (內臟利什曼原蟲病;黑熱病;kala-azar;black sickness;Burdwan fever)
11. 再生障礙性貧血 (再障)
12. 十二指腸靜脈曲張
13. 單純性血尿 (無症狀血尿;孤立性血尿;復發性血尿;asymptomatic hematuria;isolated hematuria)
14. 原發性十二指腸惡性淋巴瘤
15. 原發性骨髓纖維化
16. 同種免疫性新生兒血小板減少性紫癜 (新生兒同種免疫血小板減少性紫癜)
17. 嘔血與黑糞 (吐血與黑糞症;咯血與黑糞症;上消化道出血;嘔血與黑便;upper gastrointestinal bleeding;upper gastrointestinal hemorrhage)
18. 壞死性筋膜炎 (醫院內壞疽;急性感染性壞疽;化膿性筋膜炎;溶血性鏈球菌壞疽;皮下組織淺深靜脈的進行性壞疽)
19. 多發性骨髓瘤 (骨髓瘤;漿細胞骨髓瘤;赫珀特氏病;赫珀特病;Kahler病)
20. 妊娠合併紅細胞增多症
21. 妊娠合併自身免疫性溶血性貧血
22. 妊娠嘔吐 (早孕反應;妊娠劇吐;hyperemesis gravidarum)
23. 妊娠高血壓綜合徵 (妊高征)
24.薑片蟲病 (布氏薑片蟲病;布斯克氏薑片吸蟲病;布斯克薑片吸蟲病)
25. 嬰兒性骨皮質增生症 (嬰兒性骨皮層增生症;Caffey病;卡菲氏病;史密斯氏綜合徵;卡菲病;嬰兒骨外層肥厚;嬰兒皮質增生;史密斯綜合徵;嬰兒骨皮質肥厚症)
26. 嬰兒青銅綜合徵
27. 小兒巨幼細胞性貧血 (大細胞性貧血;大紅細胞性貧血;巨幼細胞性貧血;營養性大細胞性貧血;Macrocytic anemia;nutritional macrocytic anemia)
28. 小兒急性腎小球腎炎 (急性腎炎;急性腎炎綜合徵;急性鏈球菌感染後腎小球腎炎;acute nephritis;acute nephritic syndrome;acute poststreptococcal glomerulonephritis,APSGN;acute post-streptococcal glomerulonephritis)
29. 小兒慢性腎功能衰竭 (慢性腎衰;慢性腎衰竭;chronic renal function failure)
30. 小兒溶血性貧血
31. 小兒竇性心動過速 (竇速)
32. 小兒純紅細胞再生障礙性貧血 (純紅再障;單純紅細胞再生障礙;單純性紅細胞再生不良;純紅細胞再生障礙)
33. 小兒缺鐵性貧血 (低鐵性貧血;鐵缺乏性貧血;營養性低色素性貧血;營養性小細胞低色素性貧血;營養性缺鐵性貧血;hypoferric anemia;sideropenic anemia;nutritional iron deficiency anemia)
34. 小兒獲得性免疫缺陷綜合徵 (小兒時期的獲得性免疫缺陷綜合徵;小兒愛滋病)
35. 小兒血管網狀細胞瘤 (血管網狀內皮瘤;血管網織細胞瘤;angioreticuloendothelioma)
36. 小袋纖毛蟲病 (結腸小袋纖毛蟲病;balantidiasis coli)
37. 巨幼細胞性貧血 (巨幼紅細胞性貧血;巨幼細胞貧血;巨幼貧;惡性貧血)
38. 巴爾通體病 (秘魯疣;Oroya熱;Carrion病)
39. 急性腎盂腎炎
40. 惡性腫瘤所致貧血
41. 惡性胸腔積液
42. 新生兒RH血型不合溶血病 (新生兒母嬰血型不合溶血症;Rh溶血症)
43. 新生兒頭顱血腫 (新生兒骨膜下血腫;新生兒頭顱血腫和帽狀腱膜下出血;cephalohematoma neonatorum;subperiosteal hematoma of newborn)
44. 新生兒持續性肺動脈高壓 (持續胎兒循環;持續性胎循環;持續性肺血管閉塞;肺血管痙攣;新生兒肺缺血;持續性過渡期循環;原發性持續性肺動脈高壓;PFC;persistent fetal circulation)
45. 新生兒消化道重複症 (新生兒腸內囊腫;新生兒腸源性囊腫;新生兒胃腸道巨大憩室;新生兒不典型美克爾憩室;新生兒重複迴腸;Enterogenous cyst of newborn)
46. 新生兒紅細胞增多症-高黏滯度綜合徵 (新生兒紅細胞增多症;新生兒高黏滯度綜合徵)
47. 新生兒肛門和直腸畸形
48. 新生兒顱內出血 (新生兒顱內出血症)
49. 早產兒 (未成熟兒;早產嬰兒;preemie;preemy;prem.;premature baby)
50. 月經過多 (月經頻多)
51. 法洛四聯症 (法樂四聯症;法樂氏四聯症;法魯四聯症;四聯畸型)
52. 波-傑綜合徵 (黑斑息肉綜合徵;皮膚黏膜色素斑-胃腸道多發性息肉綜合徵;色素沉著-胃腸道多發性息肉綜合徵;Peutz-Jeghers綜合徵;P-J綜合徵;傑格斯綜合徵;普-傑二氏綜合徵;著色斑性息肉消化道綜合徵;Peutz-Jeghers syndrome)
53. 流行性出血熱 (腎綜合徵出血熱;出血性腎炎腎病;朝鮮出血熱;流行性腎病;出血性腎變病腎炎;出血熱腎病綜合徵;hemorrhagic fever with renal syndrome;HFRS;Korean haemorrhagic fever;epidemic nephropathy;nephropathia epidemica)
54. 海洛因腎臟病 (二醋嗎啡相關腎病;HAN)
55. 海藍組織細胞增生症 (海藍組織細胞綜合徵;sea-blue histocytosis)
56. 淋巴樣息肉 (良性淋巴性息肉病)
57. 混合型慢性高原病
58. 潰瘍病出血
59. 潰瘍病穿孔
60. 溶血尿毒綜合徵 (溶血性尿毒性綜合徵;血栓性微血管病;血栓性血小板減少性紫癜;血栓形成性血小板減少性紫癜;thrombotic microangiopathy;TMA; thrombotic thrombocytopenic purpura)
61. 溶血性貧血
62. 燒傷 (湯潑火傷;湯火傷;火燒瘡;灼傷)
63. 皮膚卟啉病 (紅細胞生成性原卟啉病;遲發性皮膚卟啉病;先天性紅細胞生成性卟啉病;混合性卟啉病;遺傳性糞卟啉病;皮膚性卟啉病;HC;EPP;PCT;CEP;VP)
64. 相對性紅細胞增多症
65. 真性紅細胞增多症 (真紅)
66. 硬腦膜下血腫
67. 神經性厭食 (神經性厭食症;神經性食欲不振)
68. 穩定型心絞痛 (穩定性心絞痛)
69. 糖原貯積病Ⅶ型 (糖原累積病Ⅶ型)
70. 糖尿病足
71. 紅細胞增多症眼底
72. 紅細胞增多症視網膜病變
73. 縱隔囊腫及腫瘤
74. 繼發性白血病 (治療相關骨髓增生異常綜合徵;急性髓系白血病;t-MDS/AML)
75.繼發性紅細胞增多症
76. 維生素B12選擇性吸收障礙綜合徵 (家族性選擇性維生素B12吸收不良綜合徵;先天性維生素B12吸收不良;Imerslund-Graesbeck綜合徵;Imerslund綜合徵;維生素B12選擇吸收不良綜合徵;選擇性維生素B12吸收不良綜合徵;selective vitamin B12 malabsorption syndrome)
77. 缺鐵性貧血
78. 老年人原發性血小板增多症 (老年原發性血小板增多症;老年人自發性血小板增多;老年人原發性血小板增多;senile primary thrombocythemia)
79. 老年人多發性骨髓瘤 (老年多發性骨髓瘤;老年人赫珀特病;老年人赫珀特氏病)
80. 老年人巨幼細胞性貧血 (老年巨幼細胞性貧血)
81. 老年人心源性休克 (老年心源性休克;senile cardiac shock)
82. 老年人急性淋巴細胞白血病 (老年急性淋巴細胞白血病;senile acute lympoid leukemia)
83. 老年人慢性疾病性貧血 (老年慢性疾病性貧血)
84. 老年人慢性粒細胞白血病 (老年慢性粒細胞白血病;老年人慢性髓細胞性白血病;老年人慢性粒細胞性白血病;senile chronic granulocytic leukemia)
85. 老年人慢性腎功能衰竭 (老年慢性腎功能衰竭;老年人慢性腎衰竭)
86. 老年人慢性腎盂腎炎 (老年慢性腎盂腎炎)
87. 老年人真性紅細胞增多症 (老年真性紅細胞增多症;老年人真性紅細胞增多;senile polycythemia vera)
88. 老年人缺鐵性貧血 (老年缺鐵性貧血;老年人鐵缺乏性貧血;老年人低鐵性貧血;senile hypoferric anemia;senile iron deficiency anemia;senile sideropenic anemia)
89. 老年人蛛網膜下腔出血 (老年蛛網膜下腔出血;senile subarachnoid hemorrhage)
90. 肝臟疾病所致貧血
91. 肺氣腫 (emphysema of lungs;emphysema pulmonum;pneumatosis pulmonum;pneumonectasia;pulmonary emphysema;vesicular emphysema)
92. 腎下垂
93. 胃急性擴張 (急性胃擴張)
94. 胃潰瘍
95. 胃潰瘍出血
96. 胰腺損傷
97. 胸腔積液 (胸膜滲出液;胸膜滲出;pleural effussion)
98. 腦內血管網狀細胞瘤 (血管母細胞瘤;毛細血管血管瘤;血管內皮瘤;血管外皮瘤;血管網狀內皮瘤;血管網織細胞瘤;Lindau瘤)
99. 脫水 (anhydration;dehydrolysis;dewat;dewater;dewatering)
100. 脾外傷 (脾破裂;splenic rupture)
101. 脾大 (脾腫大; enlarged spleen;splenomegalia)
102. 腹直肌自發性破裂
103. 自發性蛛網膜下腔出血 (自發性蛛網膜下出血)
104. 自身免疫性溶血性貧血 (hemolytic anemia,autoimmune)
105. 葡萄糖-6-磷酸脫氫酶缺乏症
106. 葡萄糖磷酸異構酶缺乏症
107. 血小板減少性紫癜 (原發性或特發性血小板減少性紫癜;繼發性或症狀性血小板減少性紫癜)
108. 血管-骨肥大綜合徵 (肥大性血管擴張症;血管擴張性肥大症;骨肥大症;痣-靜脈曲張骨肥大;血管-骨質增生症;皮膚脊髓血管瘤;Klippel-Trénaunay綜合徵;Parkes-Weber綜合徵;Weber綜合徵)
109. 遺傳性大皰性表皮鬆解症 (遺傳性大皰性表皮鬆解)
110. 遺傳性球形紅細胞增多症
111. 鐮狀細胞貧血 (鐮狀細胞性貧血)
112. 鐮狀細胞貧血視網膜病變 (地中海貧血;海洋貧血;Mediterranean anemia ;thalassemia)
113. 陣發性睡眠性血紅蛋白尿 (陣發性夜間血紅蛋白尿症)
114. 霍亂
115. 非內脂性網狀內皮增殖綜合徵 (韓-薛-柯綜合徵;黃脂瘤;黃瘤性肉芽腫;網狀內皮肉芽腫;類脂質貯積病;類脂沉積症;類脂質性肉芽腫;尿崩症-突眼-成骨不全綜合徵;組織細胞增生症X;網狀內皮細胞增生症;Schüller-Christian 綜合徵;Christian綜合徵; xanthomatous granuloma ; lipoid storage disease ;reticuloendothelial granuloma)
116. 非梭狀芽胞桿菌肌壞死 (厭氧鏈球菌性肌炎;streptococcus anaerobius myositis)
117. 高原心臟病 (高心病)
118. 高原紅細胞增多症 (高紅症;高海拔紅細胞增多症)
119. 高鈉血症
看懂化驗單
| 每次醫院看病,基本都離不開化驗單。你又是如何來看化驗單的呢? |